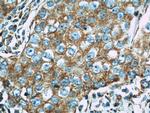
Mitofilin Antibody in Immunohistochemistry (Paraffin) (IHC (P))
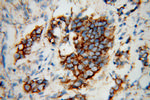
Mitofilin Antibody in Immunohistochemistry (Paraffin) (IHC (P))

Search
Proteintech
Mitofilin Polyclonal Antibody
{{$productOrderCtrl.translations['antibody.pdp.commerceCard.promotion.promotions']}}
{{$productOrderCtrl.translations['antibody.pdp.commerceCard.promotion.viewpromo']}}
{{$productOrderCtrl.translations['antibody.pdp.commerceCard.promotion.promocode']}}: {{promo.promoCode}} {{promo.promoTitle}} {{promo.promoDescription}}. {{$productOrderCtrl.translations['antibody.pdp.commerceCard.promotion.learnmore']}}
产品信息
10179-1-AP
种属反应
已发表种属
宿主/亚型
分类
类型
抗原
偶联物
形式
浓度
规格
纯化类型
保存液
内含物
保存条件
运输条件
产品详细信息
All three proteins of 87 kDa, 89 kDa, and 80 kDa can be detected in immunoblot analysis with this antibody.
Immunogen sequence: ACQLSGVTA AAQSCLCGKF VLRPLRPCRR YSTSGSSGLT TGKIAGAGLL FVGGGIGGTI LYAKWDSHFR ESVEKTIPYS DKLFEMVLGP AAYNVPLPKK SIQSGPLKIS SVSEVMKESK QPASQLQKQK GDTPASATAP TEAAQIISAA GDTLSVPAPA VQPEESLKTD HPEIGEGKPT PALSEEASSS SIRERPPEEV AARLAQQEKQ EQVKIESLAK SLEDALRQTA SVTLQAIAAQ NAAVQAVNAH SNILKAAMDN SEIAGEKKSA QWRTVEGALK ERRKAVDEAA DALLK (4-297 aa encoded by BC002412)
靶标信息
Mitofilin is a transmembrane protein of the inner mitochondrial membrane and it is associated with a large multimeric protein complex of about 1200 kDa. Mitofilin has critical functions in mitochondrial morphology and mitochondrial fusion and fission, specifically in the formation of tubular cristae and cristae junctions. Abnormal mitochondrial morphology has been implicated in many human diseases such as myopathy, cardiomyopathy, rhabdomyosarcoma and Whartin's tumor.
仅用于科研。不用于诊断过程。未经明确授权不得转售。
生物信息学
蛋白别名: Cell proliferation-inducing gene 4/52 protein; cell proliferation-inducing protein 52; heart muscle protein; IMMT; IMMT antibody; immt {ECO:0000312|EMBL:AAI05842.1, ECO:0000312|RGD:1310684}; inner mitochondrial transmembrane protein; MICOS complex subunit MIC60; mitochondrial contact site and cristae organizing system subunit 60; mitochondrial inner membrane organizing system 2; Mitochondrial inner membrane protein; mitochondrial inner membrane protein {ECO:0000250|UniProtKB:Q8CAQ8, ECO:0000312|EMBL:AAI05842.1}; Mitofilin; mitofilin {ECO:0000250|UniProtKB:Q8CAQ8}; motor protein; p87/89; p87/89 antibody; PIG4; PIG52; proliferation-inducing gene 4; unnamed protein product
基因别名: 1700082C19Rik; D830041H16Rik; HMP; IMMT; MIC60; MICOS60; MINOS2; P87; P87/89; P89; PIG4; PIG52
UniProt ID: (Human) Q16891, (Rat) Q3KR86, (Mouse) Q8CAQ8
Entrez Gene ID: (Human) 10989, (Rat) 312444, (Mouse) 76614